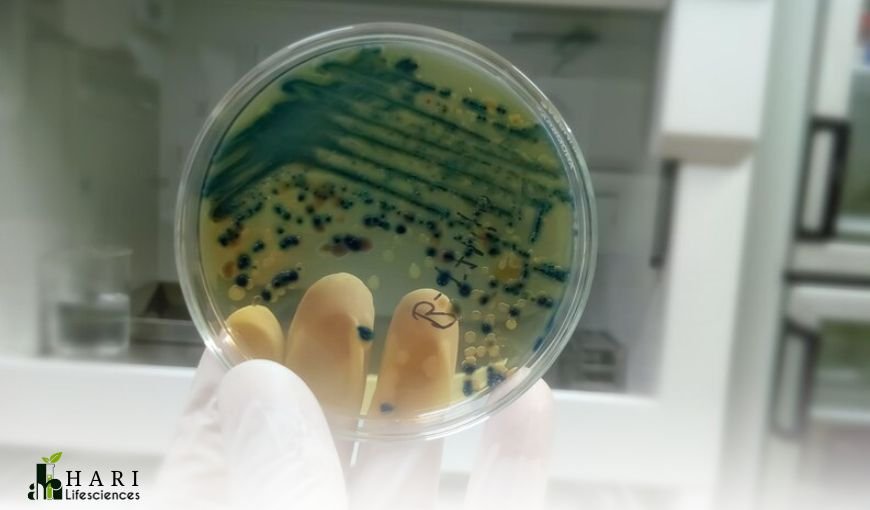

-
Title:
Medicinal Mushroom Cultivation
-
Date::
September 12,2016
-
City:
Bhopal
-
Category:
Mycology
-
Place:
Hari lifescience
Project Description
Welcome to our cutting-edge research lab nestled in the heart of Central India's thriving city, Bhopal. With a profound focus on medicinal mushrooms, such as Cordyceps militaris, Ganoderma lucidum, Lion's Mane, and a diverse array of other potent species, we stand at the forefront of innovative cultivation techniques. Our team of experts possesses unparalleled expertise in growing these remarkable fungi, renowned for their numerous health benefits and therapeutic properties. However, our commitment doesn't end with scientific excellence. We are devoted to nurturing the entrepreneurial spirit within individuals who wish to embark on a rewarding journey in the medicinal mushroom industry.
Our comprehensive training programs impart valuable knowledge and practical skills, equipping aspiring entrepreneurs to establish and manage their mushroom cultivation ventures successfully. Whether you are an enthusiast with a passion for holistic wellness or an experienced grower seeking to diversify your agricultural pursuits, our lab promises to be your trusted partner in realizing your entrepreneurial dreams through the power of medicinal mushrooms. Together, we aim to cultivate not only these exceptional fungi but also a healthier and more prosperous future for all.